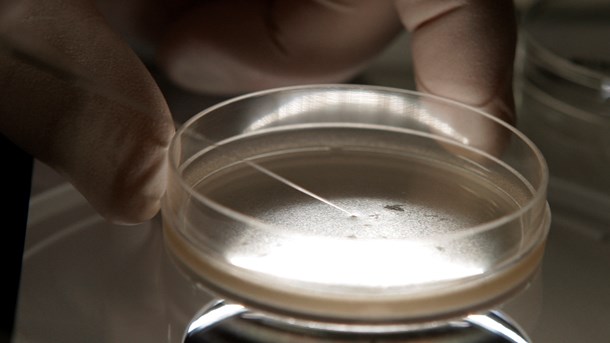
Fra fond til forsker: Stamcelleprojekt får 7,6 millioner fra norsk fond

Astrid Johanne Bjørnskov
Redaktionsassistent
Artikler af og om Astrid Johanne Bjørnskov
København | Stockholm | Oslo | Bruxelles
Vi tror på politik
AdresseNy Kongensgade 101472 København KTlf. 33 34 35 40redaktionen@altinget.dkCVR nr.: 29624453ISSN: 2597-0127
Ansv. chefredaktørJakob NielsenDirektørAnne Marie KindbergCFOAnders JørningKommerciel direktørMichael Thomsen
Copyright © Altinget, 2026